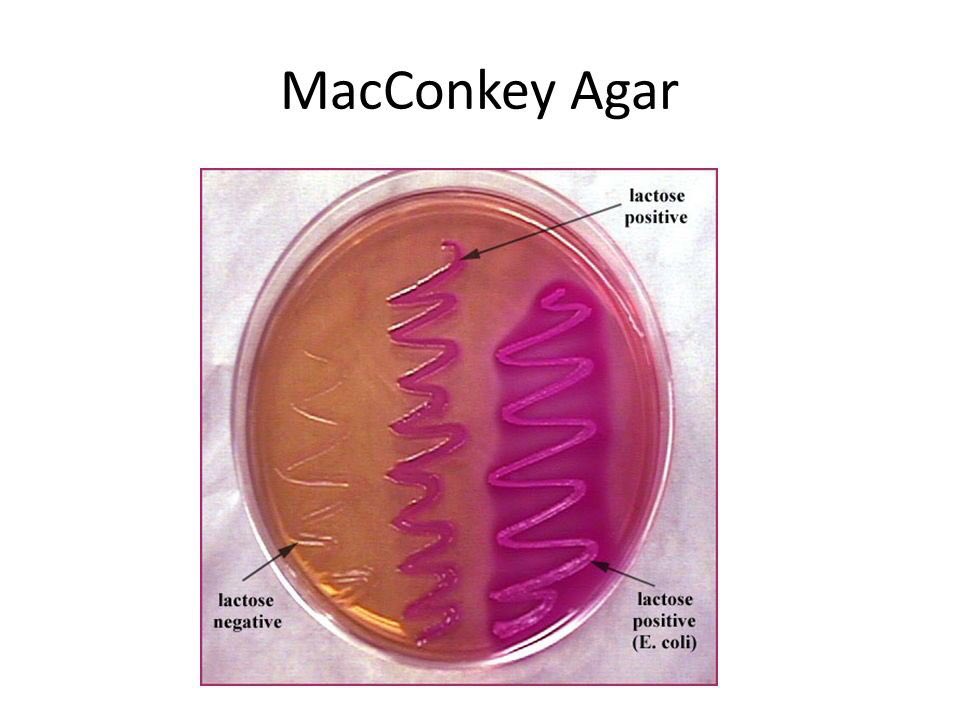

E coli тест
Map mirea
You re the one на русский
Ro cat наполнитель
Детский лагерь в санкт петербурге
Проектирование учебно воспитательной деятельности
Байкал на карте атласа
Как закоптить свиную грудинку горячее копчение
Dv 668av
Сообщение тема язык и речь культура речи
Приходкин
Яковлевка днр
Адреса мебельных магазинов в белгороде
Подозерова кухня
E coli тест 114 фото